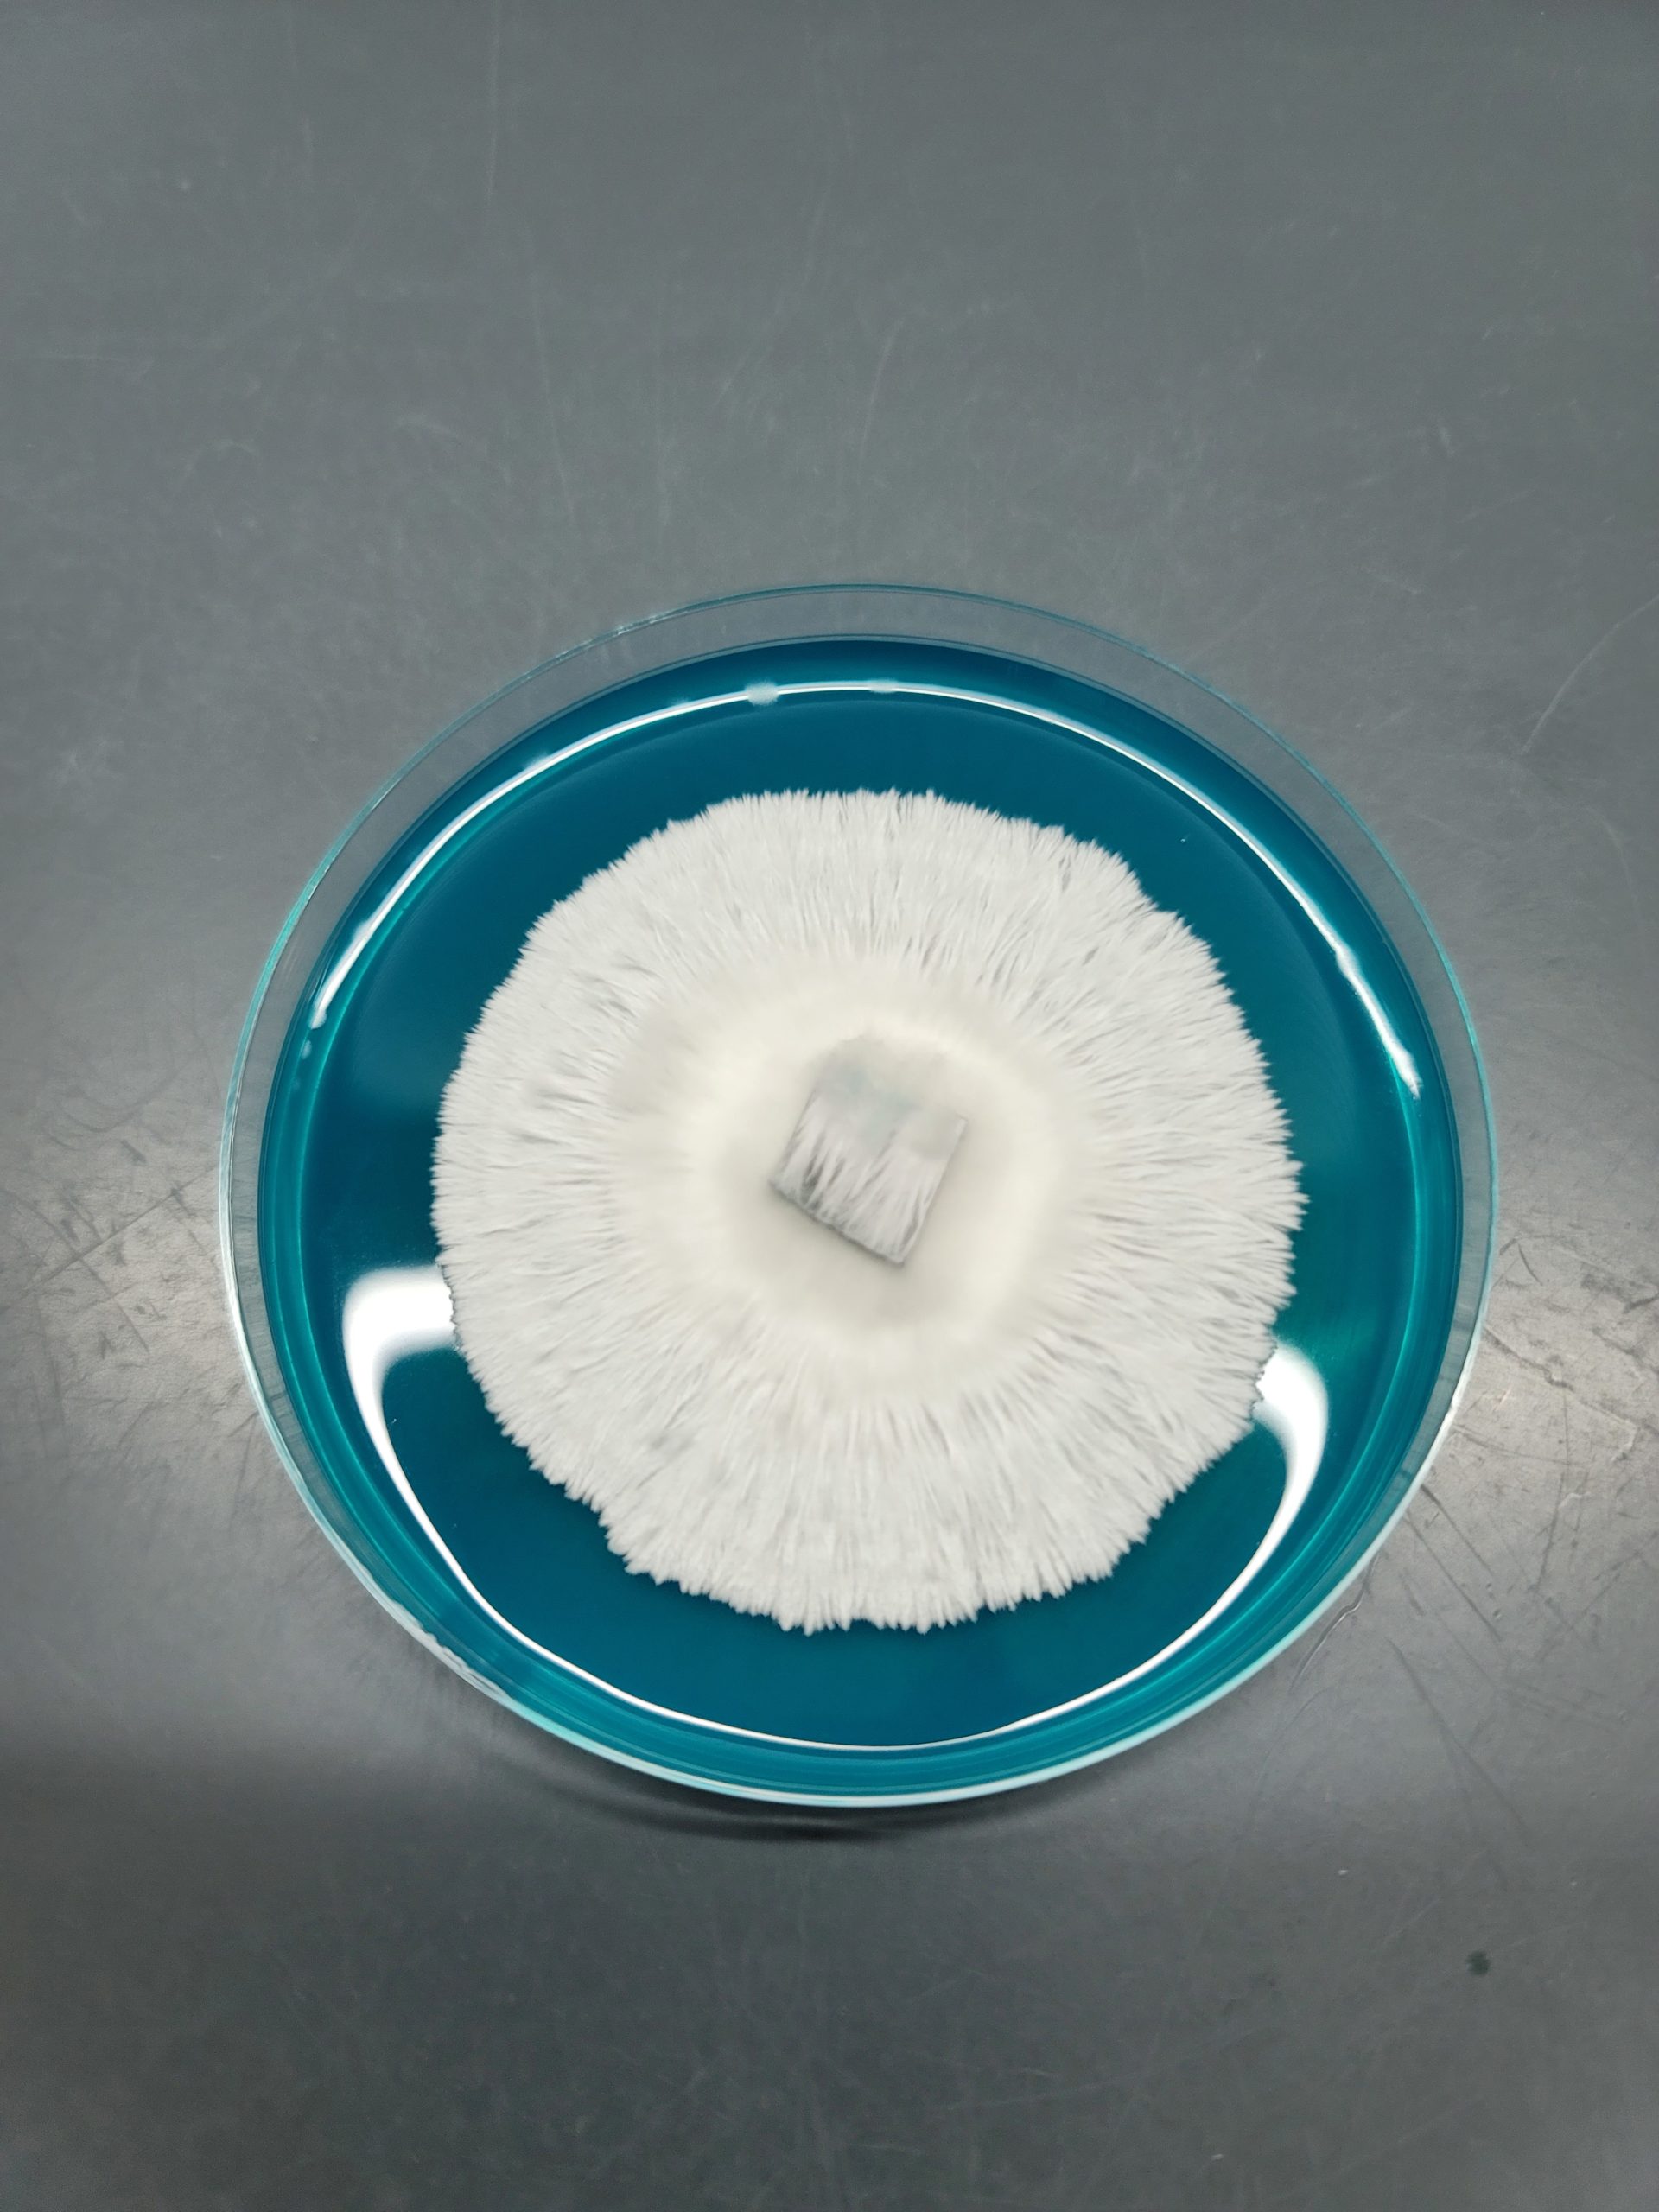
Albino Burma - Isolated Plate

Description
Albino Burma – Isolated Plate
For a Limited Time, Basidium Equilibrium is offering this phenomenal, Albino Burma – Isolated Plate.
Strain origin – The Burma strain originates from Southeastern Asia in its namesake, Burma, a country between Thailand and India.
- Gill formation – Gills typically are medium to large, wide range of formation. Not likely to have available gills for spore release.
- Microscopic features – Clear Spores. Spores measure 7 x 12 micrometers. This variety Albino Burma cubensis does not discharge spores during sporulation and has taken on Albino characters and coloration. Spores can be swabbed to be observed under magnification. Germination of spores will often be observed having clamp connections and fine feathered mycelium. Microscopes and magnification equipment are recommended for viewing microscopic features
- Rare varieties of psilocybe cubensis will be retired in the Genetic Vault. Check out the Vault for more unique collectable varieties! Affiliated mycology businesses that offer lab equipment and tools visit basmycology.com
Spores intended for microscopy, taxonomy and novelty purposes only. Informational and educational reference only and originate from cultivators and labs outside the US. Cultivation of this species is illegal in many countries including the United States. Please check your local regulations. California, Idaho, and Georgia resident Orders requesting Psilocybe Genera Spores shipped to California, Idaho, and Georgia will be refused.

Reviews
There are no reviews yet.